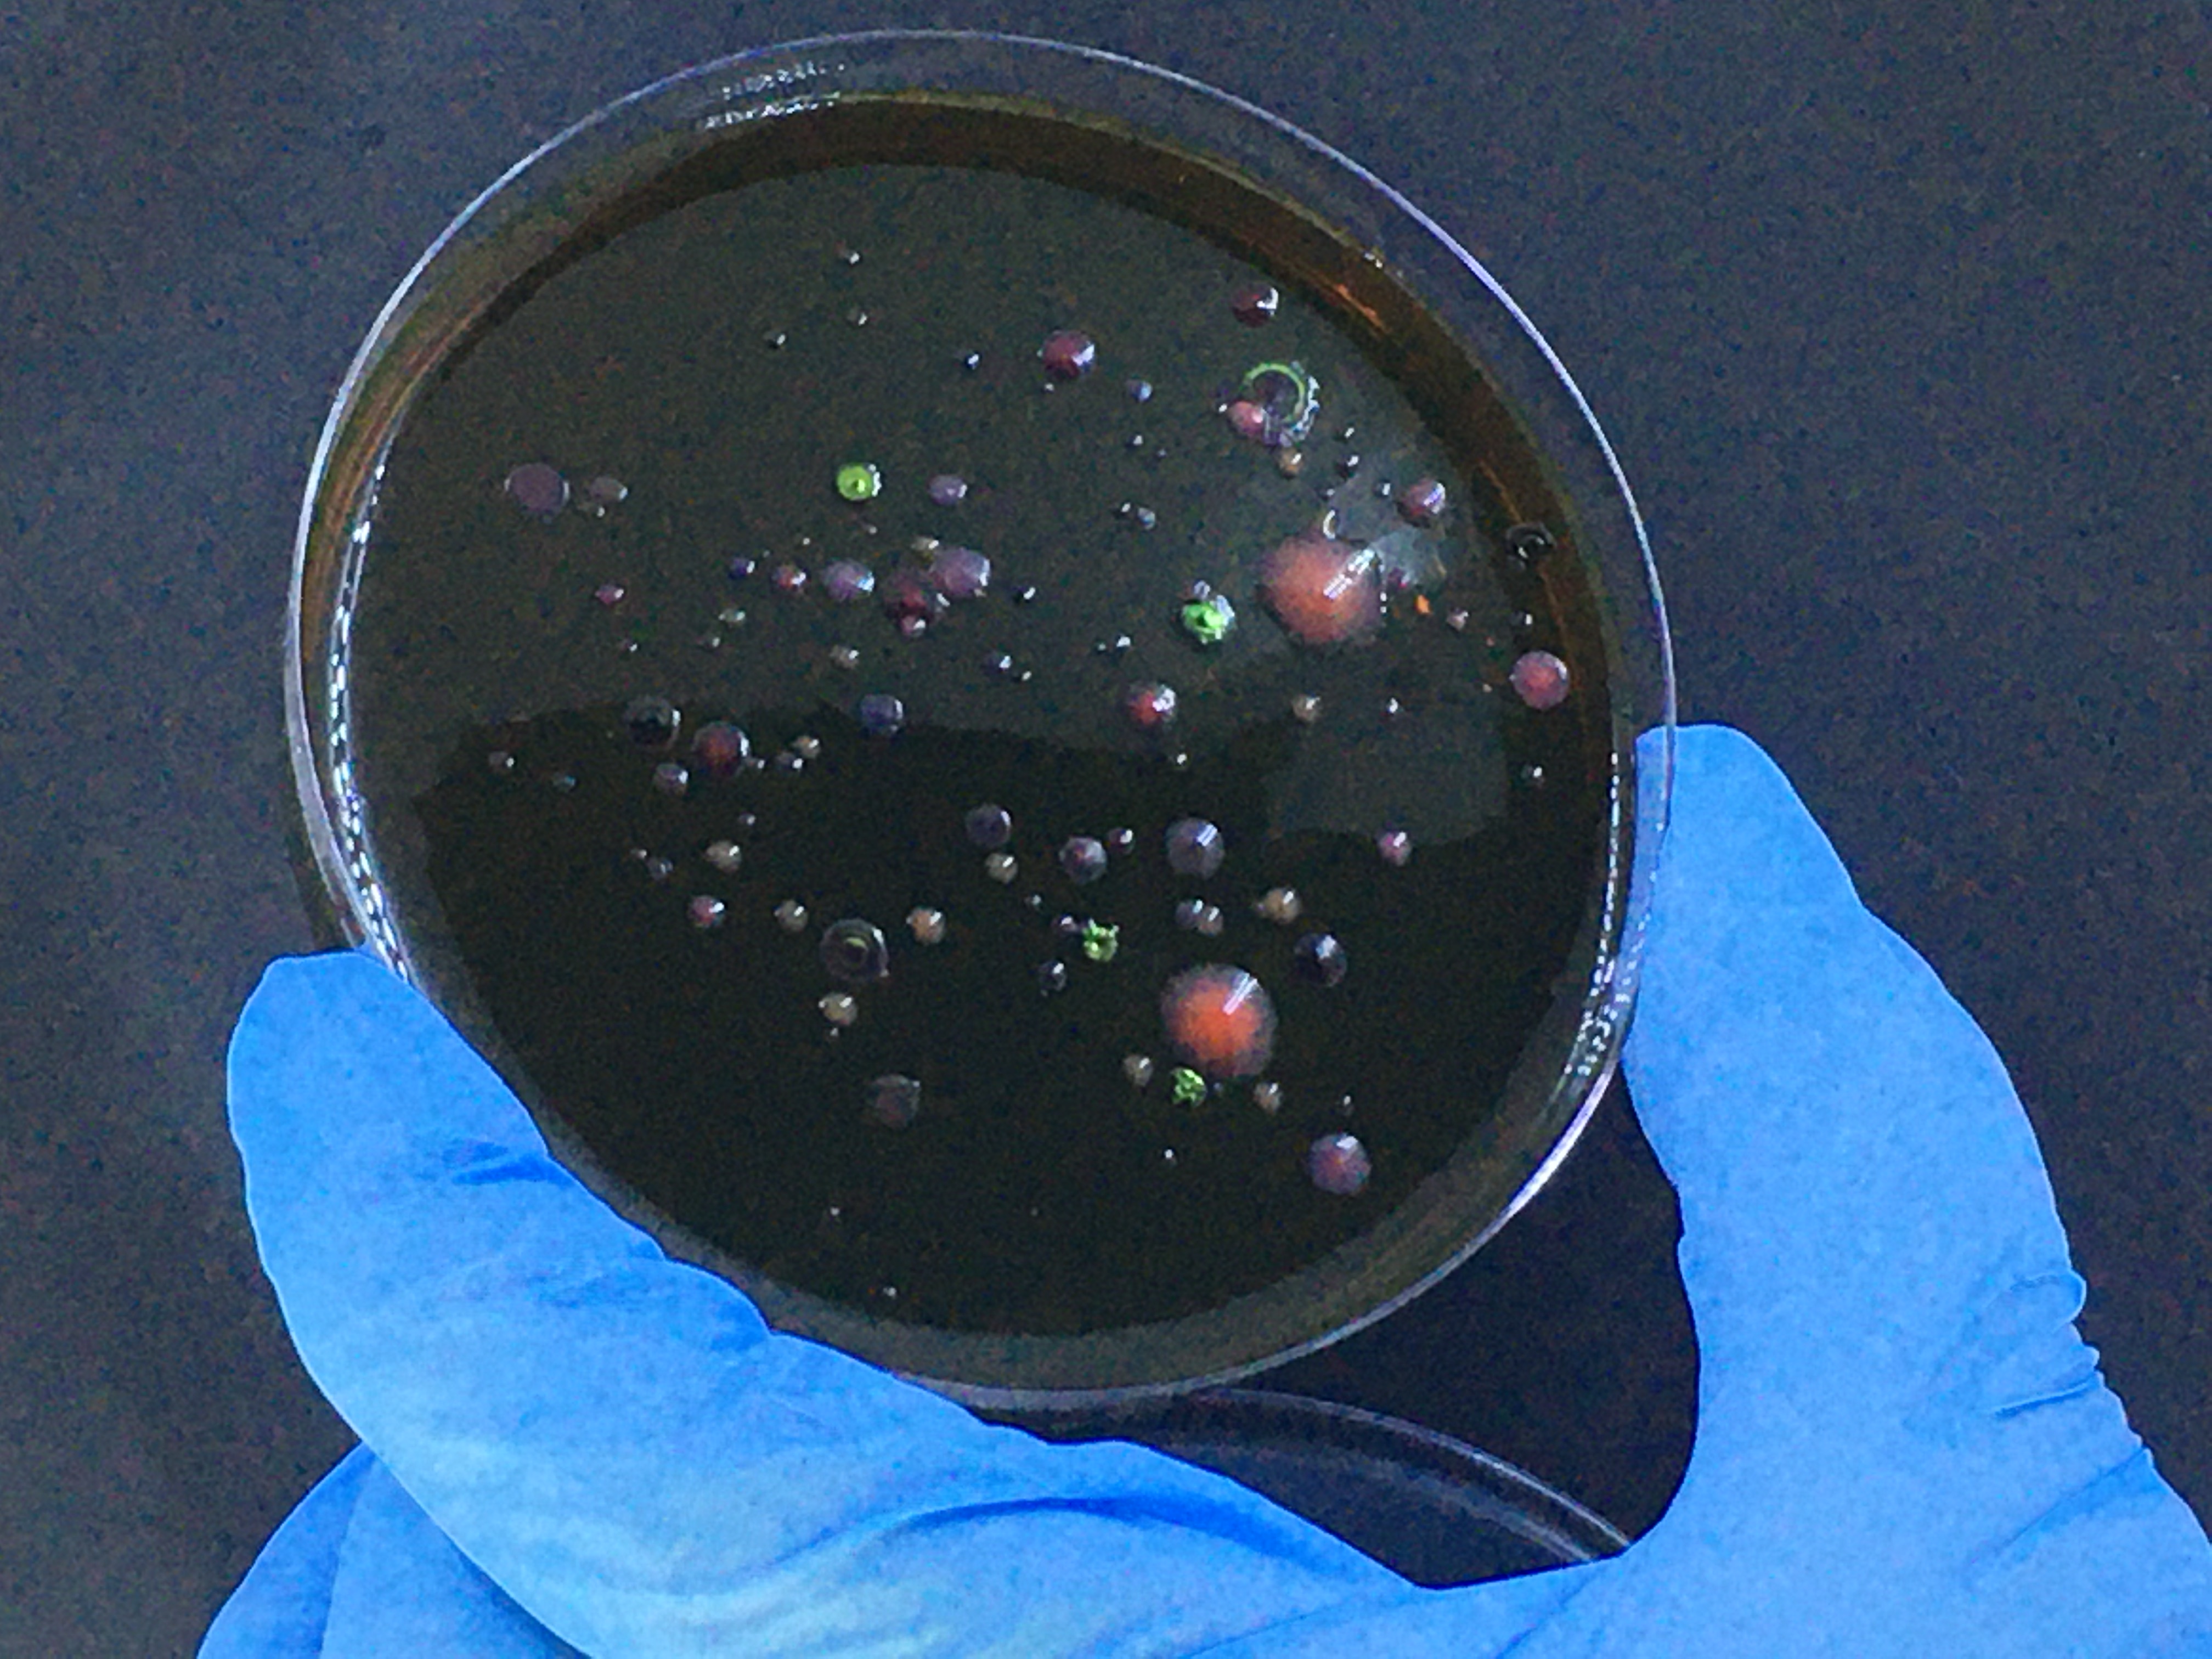

Lead author Rachel Aronoff recalls her discovery of Hackuarium, a community laboratory, whose study on lake water quality demonstrates how meaningful environmental monitoring can be achieved with participatory research.
It was late in 2015 when I first encountered Hackuarium and its ‘biohacker’ members while organising a biosensor course in collaboration with several of its members – I had never seen anything like it.
Who were these students, engineers, post-docs, artists, makers and members of the public, I wondered. How could this big space with a large workshop and ‘coworking’ areas run successfully? What were those lampshades made out of? (Turned out to be mycelia cultures on straw, a biomaterial that has been proposed as an alternative to Styrofoam).
Hackuarium is a community lab association which promotes open science and aims to democratise research for anyone. At Hackuarium, I was inspired by open documentation of experiments done by trans-disciplinary teams, sharing not just knowledge, but know-how. We soldered simple fluorescence detectors for the biosensor course. One Hackuarium member, who designed the detector, had also made and used a simple Geiger counter in Japan in the aftermath of the Fukushima disaster!
My largely academic path, full of ideas and molecular puzzles, was toppled by this introduction to open and frugal science.

Hackuarium could provide a physical venue for experimental work, it seemed, in ways I had never before considered. Now after more than 3 years as president of Hackuarium, my current big challenge, besides dreams to impact public health with AGiR! and the current Corona Detective project, is to make community labs more widespread and envision ways for them to become sustainable.
Monitoring Lake Geneva
One participant at the biosensor course had founded the association Hammerdirt, a non-profit organisation dedicated to collecting, analysing and distributing environmental data. As lifeguards in a small Swiss city called Montreux, famous for its Jazz music festival on Lake Geneva, he and his colleagues suffered each summer from skin and gastrointestinal issues.
We discussed their concerns about summertime pollution in a brainstorming session during this special #OpenHackuarium evening which ultimately led to our recent ESE publication examining raw sewage levels in the bay and confirmed the idea that pollution peaks in the bay correlated with the timing of the music festival.
Over two consecutive summers in 2016/2017, our volunteer group sampled three sites around Montreux Bay to track pollution using classic microbiological methods with a twist – extra colours (and even fluorescence).
We found that bioindicator (bacterial colony-forming unit (CFU)) concentration increased almost five-fold from low baseline levels (30-80 CFU/100ml of water) during the two weeks of the festival. Even though Swiss federal limits for recreational waters are 100 CFU/100ml, during the festival we found 2.5-fold that amount on average.
Over a 2-week period, the presence of 200,000 additional people has its ramifications, particularly in a small city with a sewage treatment system built for a population of 35,000.
We also found that during the pandemic summer season of 2020, when the music festival was cancelled, only rare instances of lower level pollution were observed. Including this additional sampling in our analyses was essential for getting this work out (as shown in the infographic below).

However, Montreux bay is not ordinarily tested by the city’s industrial services as it is not a swimming beach, even though official results from the beaches at either end of the bay were consistent with our findings. Furthermore, European limits for water quality are less stringent, with up to 500 CFU/100ml of bioindicator bacteria allowed in recreational water (To note: Lake Geneva is on the border between Switzerland and France). Nonetheless, we observed more than 800 CFU/100ml in the course of the study.
Our research thus raises many questions. How are limits of pollution decided? Are only swimming beaches most important to monitor? Is management of seasonal pollution feasible? Can local participatory research, anywhere, really make a difference? How can support for such work be increased, as a sustainable model cannot fully rely upon volunteers without reward?
We nevertheless learned immensely from this work and hope it will encourage others to do more participatory research, especially as academic support for local studies is limited and official environmental monitoring systems have difficulties.
Since publication, we have sent a letter to Montreux city officials, organisers of the jazz festival, workers at the sewage treatment plant, other researchers and the international body responsible for recreational water quality (CIPEL), offering to share experiences, coach or collaborate on future monitoring around the bay (perhaps by a local group for the 2022 season).
How others might make the most of this example and join us in learning more, remains in question.
I believe we can all benefit from more community-based research and hope others use our example as a spring-board to learn more and join in to contribute to such initiatives. I also hope open science will become a sustainable force to help our society solve some of the challenges with which we are faced.
Read the full article: “Participatory research to monitor lake water pollution” in Issue 2:3 of Ecological Solutions and Evidence.
Discover more articles from our cross-journal Special Feature on Citizen Science.